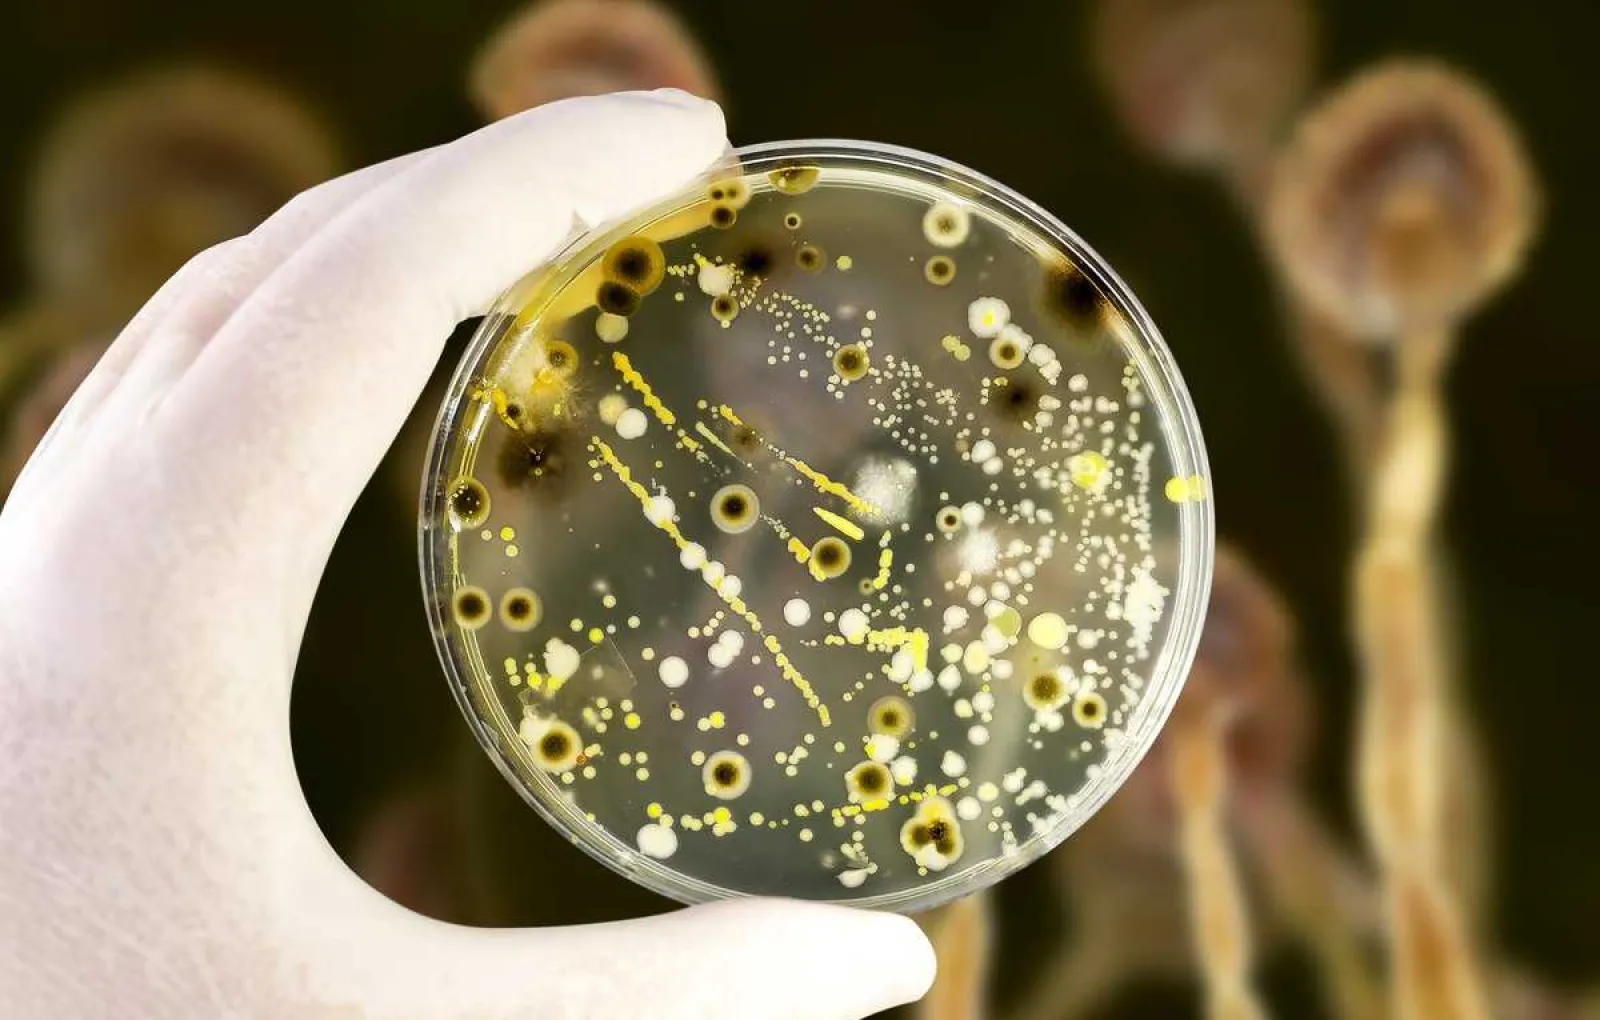

Примеры микробиологического загрязнения окружающей среды

Раздел: Другие животные